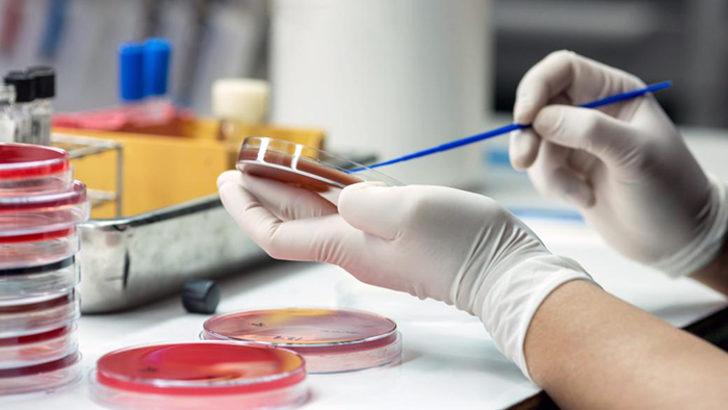
O bakteriyi kendisine enjekte etti: Hiç bu kadar iyi hissetmedim! G3

0% Faizli Fırsat!

Faiz Oranı
%0
Vade
3 Ay
Toplam Tutar
100.000 TL

Sibirya’nın Yakutsk bölgesindeki Mamut Dağı eteklerinde Bacillus F adı verilen, 3.5 milyon yıllık bir bakteri keşfedildi. Moskova Devlet Üniversitesi’nde görevli olan akademisyen Anatoli Brouchkov, üzerinde 3 yıl boyunca sürdürdüğü araştırmaların ardından bakterinin gençleştirici ve bağışıklık sistemini güçlendirici özelliklerine sahip olduğunu keşfetti. 2012 yılında farelere enjekte ettiği bakterinin işe yaramasının ardından 3 yıl önce de kendi üzerinde denemeye karar verdi.
ÖNCE FARELERE SONRA KENDİNE ENJEKTE ETTİ
Moskova Devlet Üniversitesi’nde görevli bilim insanı Anatoli Brouchkov, 2009 yılında Sibirya’da bir buzulun altında 3.5 milyon yaşında bir bakteri keşfetti. Brouchkov bulduğu bakteriyi önce farelere sonra da kendisine enjekte etti.
'SON 2 YILDIR GRİP BİLE OLMUYORUM'
Bunu yaparak test çalışmasını da başlatmış olan Brouchkov, bakteriyi kendisine enjekte etmenin üzerinde nasıl bir etki yarattığını şu cümlelerle açıklıyor: “Daha çok çalışmaya başladım. Son iki yıldır bırakın hasta olmayı grip bile olmuyorum. Fareler ve meyve sinekleri üzerinde yapılan başarılı deneylerin ardından, aktive edilmemiş bakteri kültürünü denemenin ilginç olacağını düşündüm” diyor. Kısaca özetlemek gerekirse, Brouchkov bu işlemi “sadece meraklıydım, dünyaya bir kere geliyoruz” diye ifade ediyor.
YAKUT TÜRKLERİNİN UZUN YAŞAMASININ SIRRI BU OLABİLİR
Yakut Türklerinin uzun yaşamasının sırrının bölgedeki sulara karışan bu bakterinin olduğunu düşünen Brouchkov, bakterinin insan vücudundaki pozitif etkileri konusunda ise ellerinde net bir veri olmadığını söylüyor. Rus bilim insanı “Gerçekte aspirinin de nasıl işe yaradığını bilmiyoruz, ancak bir şekilde yarıyor. Aynı şey bu bakteri için de geçerli. Mekanizmasını anlayamıyoruz, ancak sonuçlarını görüyoruz. Bakterinin çalışma mekanizmasını anlamak istiyoruz. Ölümsüz bakterilerin ve canlıların olduğunu ve bu bakterilerin kendilerini koruyabildikleri için ölmediklerini düşünüyoruz” diyor.
BU BAKTERİ DOĞURGANLIĞI DA ARTTIRIYOR
Fareler üzerinde yaptığı deneyde bakterilerin doğurganlığı arttırdığı, hatta doğurgan olmayan yaşlı farelerin de üremeye başladığı tespit edildi. Bakterinin gençleştirici etkisiyle ilgili Siberian Times gazetesine bir açıklamada bulunan Dr. Viktor Chernyavsky, “Bu bakterinin biyolojik olarak salgıladığı aktif maddeler kobay farelerin bağışıklık sistemini güçlendiriyor. Bu salgılar doğurganlığı da artırıyor” şeklinde konuşuyor.
YAŞADIKLARI PLACEBO ETKİSİ DE OLABİLİR
Bacillus F bakterisinin Brouchkov üzerindeki etkileri placebo etkisi olabilir, ancak gerçek olma ihtimalini de göz ardı edemeyiz. Bu bakterinin insan ömrünü uzatıp uzatmayacağını anlamak için daha fazla araştırmaya ihtiyaç duyuyoruz. Ancak eğer Dr. Brouchkov 1000 yaşını görürse o zaman elimizde tartışmasız bir kanıt var diyebiliriz.